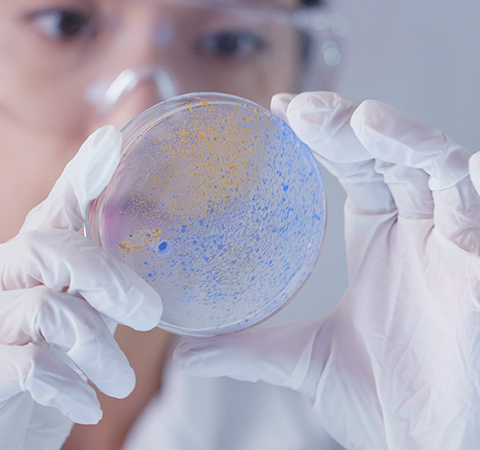

IDT
Genes and Gene Fragments
합성 생물학 및 분자 생물학 응용 분야를 위한 DNA fragment 및 클로닝 유전자
IDT는 실험적 요구를 충족하는 신뢰할 수 있는 다양한 솔루션을 제공합니다
제품소개
-
- eBlocks™ Gene Fragments
- 항체 발견 워크플로우를 위한 다중 구조의 고처리량 스크리닝(HTS)에 적합합니다.
-
- gBlocks™ 및 gBlocks HiFi Gene Fragments
- 항체 발견 워크플로우를 위한 다중 구조의 고처리량 스크리닝(HTS)에 적합합니다.
-
- 유전자 합성
- 저렴하고 쉬운 유전자 구성 또는 수정, qPCR/NGS 제어 등을 위해 설계되었습니다.
-
- Rapid Genes
- 즉시 사용 가능한 NGS 검증 클론 유전자로, 고처리량 스크리닝 실험에 빠르게 들어가는 데 적합합니다.
-
- Megamer™ ssDNA Fragments
- CRISPR 매개 게놈 편집의 동족 지향 복구, 시험관 내 전사 등과 같은 연구 응용 분야에서 사용할 수 있습니다.